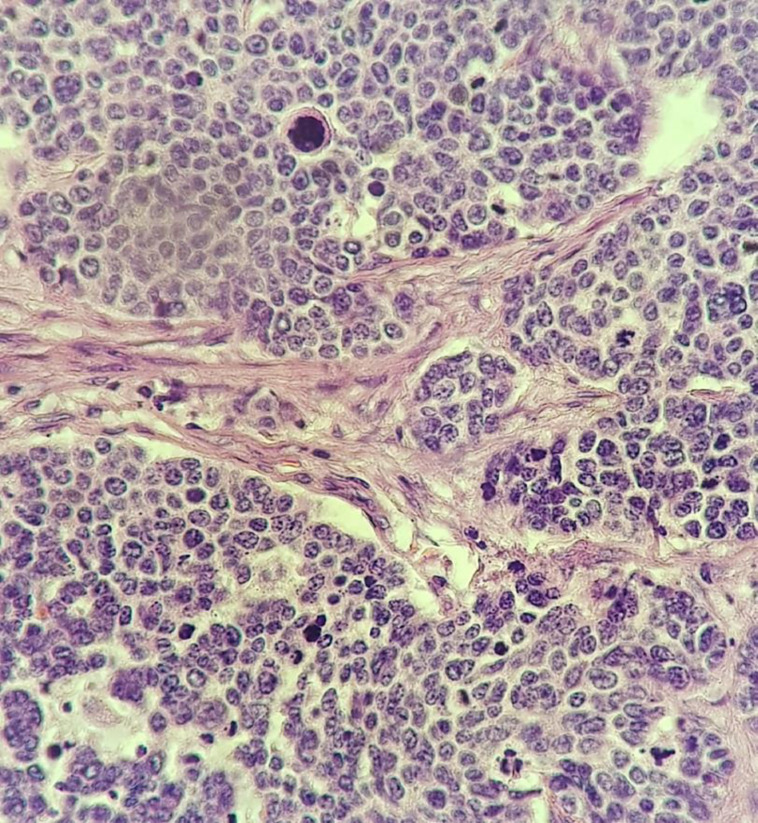

Small cell carcinoma of uterine cervix: A case report.
IF 1
Q3 MEDICINE, GENERAL & INTERNAL
引用次数: 0
Abstract
Background: Small cell carcinoma of cervix (SCCC) is a rare disease. SCCC is highly invasive and prone to distant metastatic spread and lymph node involvement. Here we aim to present a patient and her treatment.
Case presentation: We report 47-year-old patient with history of breast cancer manifesting with abnormal vaginal bleeding diagnosed with SCCC. Patient underwent radical hysterectomy and bilateral salpingo-oophorectomy. Then, she received adjuvant chemoradiation postoperatively.
Conclusion: Small cell carcinoma of cervix is an aggressive form of cervical cancer with poor prognosis. Optimal treatment remains unsettled.

子宫颈小细胞癌:病例报告
背景:宫颈小细胞癌(SCCC)是一种罕见疾病。SCCC 侵袭性强,易发生远处转移和淋巴结受累。在此,我们旨在介绍一名患者及其治疗情况:我们报告了一名 47 岁的患者,她曾患乳腺癌,并伴有异常阴道出血,被诊断为 SCCC。患者接受了根治性子宫切除术和双侧输卵管切除术。术后接受了辅助化疗:结论:宫颈小细胞癌是一种侵袭性宫颈癌,预后较差。结论:宫颈小细胞癌是一种预后较差的侵袭性宫颈癌,其最佳治疗方法仍未确定。
本文章由计算机程序翻译,如有差异,请以英文原文为准。
求助全文
约1分钟内获得全文
求助全文
来源期刊

Caspian Journal of Internal Medicine
MEDICINE, GENERAL & INTERNAL-
CiteScore
1.90
自引率
7.10%
发文量
90
审稿时长
20 weeks
 求助内容:
求助内容: 应助结果提醒方式:
应助结果提醒方式:


